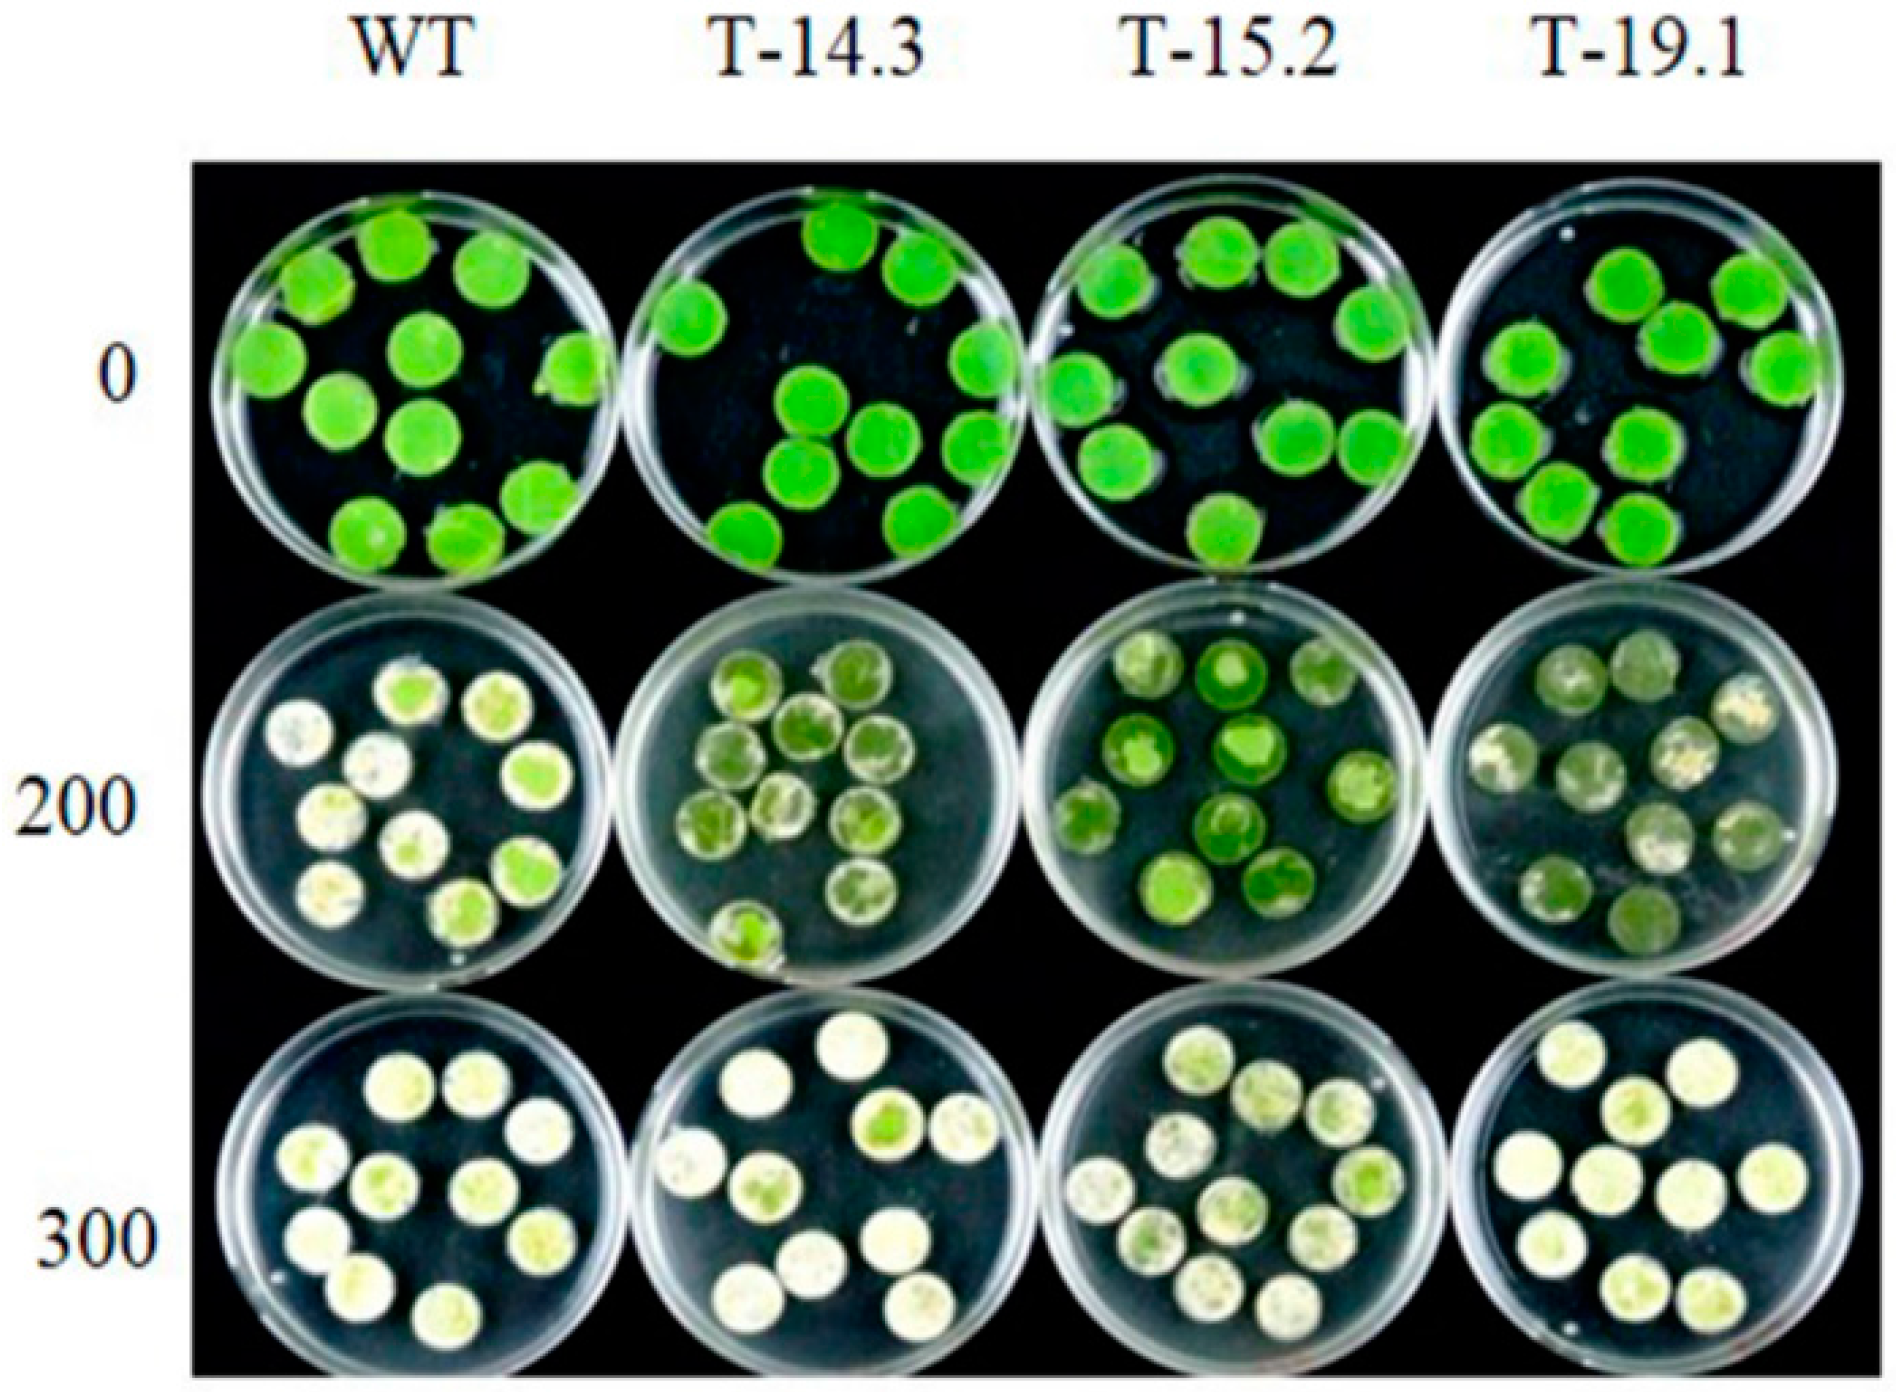

Overexpression of Arabidopsis AnnAt8 Alleviates Abiotic Stress in Transgenic Arabidopsis and Tobacco
Abstract
:1. Introduction
2. Materials and Methods
2.1. AnnAt8 Construct Preparation
2.2. Plant Material and Experimental Conditions
2.3. Plant Transformation
2.4. Seed Germination Analysis in Salt and Osmotic Stress
2.5. Seedling Stress Assay
2.6. Leaf Disc Senescence Assay
2.7. Biochemical Analyses: Determination of Chlorophyll Content and Lipid Peroxidation Assay
2.8. Estimation of Proline Content in Transgenic and WT Tobacco Seedlings
2.9. Real Time Expression Analysis of Stress-Inducible Genes in WT and Transgenic Tobacco Plants
2.10. Subcellular Localization of AnnAt8 Protein
2.11. Statistical Analysis
3. Results
3.1. Molecular Analysis of Transgenic Arabidopsis and Tobacco Plants
3.2. Enhanced Seed Germination of Arabidopsis Transgenic Plants under Stress Conditions
3.3. Salt and Dehydration Stress Tolerance of AnnAt8 Transgenic Arabidopsis Plants
3.4. Osmotic and Salt Stress Tolerance of AnnAt8 Transgenic Tobacco Plants
3.5. Alleviation of Methyl Viologen Stress in AnnAt8 Transgenic Tobacco Plants
3.6. Enhanced Tolerance of AnnAt8 Transgenic Tobacco Plants to Osmotic Stress Condition
3.7. Enhanced Root Growth of AnnAt8 Transgenic Tobacco Seedlings under Salt and Dehydration Stress
3.8. Expression Analysis of Stress Related Genes in Transgenic and WT Tobacco Seedlings
3.9. Subcellular Localization of GFP-Tagged AnnAt8 Protein in Tobacco Cells
4. Discussion
4.1. AnnAt8 Is Involved in Salt and Dehydration Stress Tolerance
4.2. AnnAt8 Is Involved in Alleviation of Methyl Viologen Induced Stress
4.3. Localization Patterns of AnnAt8
4.4. How Does AnnAt8 Respond to Abiotic Stress?
5. Conclusions
Supplementary Materials
Acknowledgments
Author Contributions
Conflicts of Interest
Abbreviations
References
- Wang, W.; Vinocur, B.; Altman, A. Plant responses to drought, salinity and extreme temperatures: Towards genetic engineering for stress tolerance. Planta 2003, 218, 1–14. [Google Scholar] [CrossRef] [PubMed]
- Apel, K.; Hirt, H. Reactive oxygen species: Metabolism, oxidative stress, and signal transduction. Annu. Rev. Plant Biol. 2004, 55, 373–399. [Google Scholar] [CrossRef] [PubMed]
- Hasegawa, P.M. Sodium (Na+) homeostasis and salt tolerance of plants. Environ. Exp. Bot. 2013, 92, 19–31. [Google Scholar] [CrossRef]
- Hirayama, T.; Shinozaki, K. Research on plant abiotic stress responses in the post-genome era: Past, present and future. Plant J. 2010, 61, 1041–1052. [Google Scholar] [CrossRef] [PubMed]
- Shavrukov, Y. Salt stress or salt shock: Which genes are we studying? J. Exp. Bot. 2013, 64, 119–127. [Google Scholar] [CrossRef] [PubMed]
- Claeys, H.; Van Landeghem, S.; Dubois, M.; Maleux, K.; Inzé, D. What is stress? Dose-response effects in commonly used in vitro stress assays. Plant Physiol. 2014, 165, 519–527. [Google Scholar] [CrossRef] [PubMed]
- Moss, S.; Morgan, R. The annexins. Genome Biol. 2004, 5. [Google Scholar] [CrossRef] [PubMed]
- Clark, G.B.; Morgan, R.O.; Fernandez, M.P.; Roux, S.J. Evolutionary adaptation of plant annexins has diversified their molecular structures, interactions and functional roles. New Phytol. 2012, 196, 695–712. [Google Scholar] [CrossRef] [PubMed]
- Gerke, V.; Creutz, C.E.; Moss, S.E. Annexins: Linking Ca2+ signalling to membrane dynamics. Nat. Rev. Mol. Cell Biol. 2005, 6, 449–461. [Google Scholar] [CrossRef] [PubMed]
- Jami, S.K.; Clark, G.B.; Ayele, B.T.; Ashe, P.; Kirti, P.B. Genome-wide comparative analysis of annexin superfamily in plants. PLoS ONE 2012, 7, e47801. [Google Scholar] [CrossRef] [PubMed]
- Davies, J. Annexin-mediated calcium signalling in plants. Plants 2014, 3, 128–140. [Google Scholar] [CrossRef]
- Clark, G.B.; Sessions, A.; Eastburn, D.J.; Roux, S.J. Differential expression of members of the annexin multigene family in Arabidopsis. Plant Physiol. 2001, 126, 1072–1084. [Google Scholar] [CrossRef] [PubMed]
- Hofmann, A. Annexins in the plant kingdom: Perspectives and potentials. Annexins 2004, 1, 51–61. [Google Scholar]
- Huh, S.M.; Noh, E.K.; Kim, H.G.; Jeon, B.W.; Bae, K.; Hu, H.C.; Kwak, J.M.; Park, O.K. Arabidopsis annexins AnnAt1 and AnnAt4 interact with each other and regulate drought and salt stress responses. Plant Cell Physiol. 2010, 51, 1499–1514. [Google Scholar] [CrossRef] [PubMed]
- Wang, X.; Ma, X.; Wang, H.; Li, B.; Clark, G.; Guo, Y.; Roux, S.; Sun, D.; Tang, W. Proteomic study of microsomal proteins reveals a key role for Arabidopsis annexin 1 in mediating heat stress-induced increase in intracellular calcium levels. Mol. Cell. Proteom. 2015, 14, 686–694. [Google Scholar] [CrossRef] [PubMed]
- Zhu, J.; Yuan, S.; Wei, G.; Qian, D.; Wu, X.; Jia, H.; Gui, M.; Liu, W.; An, L.; Xiang, Y. Annexin5 is essential for pollen development in arabidopsis. Mol. Plant 2014, 7, 751–754. [Google Scholar] [CrossRef] [PubMed]
- Zhu, J.; Wu, X.; Yuan, S.; Qian, D.; Nan, Q.; An, L.; Xiang, Y. Annexin5 plays a vital role in Arabidopsis pollen development via Ca2+-dependent membrane trafficking. PLoS ONE 2014, 9, e102407. [Google Scholar]
- Jia, F.; Wang, C.; Huang, J.; Yang, G.; Wu, C.; Zheng, C. SCF E3 ligase PP2-B11 plays a positive role in response to salt stress in Arabidopsis. J. Exp. Bot. 2015, 66, 4683–4897. [Google Scholar] [CrossRef] [PubMed]
- Mortimer, J.C.; Laohavisit, A.; Macpherson, N.; Webb, A.; Brownlee, C.; Battey, N.H.; Davies, J.M. Annexins: Multifunctional components of growth and adaptation. J. Exp. Bot. 2008, 59, 533–544. [Google Scholar] [CrossRef] [PubMed]
- Konopka-Postupolska, D.; Clark, G.; Goch, G.; Debski, J.; Floras, K.; Cantero, A.; Fijolek, B.; Roux, S.; Hennig, J. The role of Annexin 1 in drought stress in Arabidopsis. Plant Physiol. 2009, 150, 1394–1410. [Google Scholar] [CrossRef] [PubMed]
- Lee, S.; Lee, E.J.; Yang, E.J.; Lee, J.E.; Park, A.R.; Song, W.H.; Park, O.K. Proteomic identification of annexins, calcium-dependent membrane binding proteins that mediate osmotic stress and abscisic acid signal transduction in Arabidopsis. Plant Cell Online 2004, 16, 1378–1391. [Google Scholar] [CrossRef] [PubMed]
- Qiao, B.; Zhang, Q.; Liu, D.; Wang, H.; Yin, J.; Wang, R.; He, M.; Cui, M.; Shang, Z.; Wang, D.; et al. A calcium-binding protein, rice annexin OsANN1, enhances heat stress tolerance by modulating the production of H2O2. J. Exp. Bot. 2015, 66, 5853–5866. [Google Scholar] [CrossRef] [PubMed]
- Zhou, M.L.; Yang, X.B.; Zhang, Q.; Zhou, M.; Zhao, E.Z.; Tang, Y.X.; Zhu, X.M.; Shao, J.R.; Wu, Y.M. Induction of annexin by heavy metals and jasmonic acid in Zea mays. Funct. Integr. Genom. 2013, 13, 241–251. [Google Scholar] [CrossRef] [PubMed]
- Laohavisit, A.; Davies, J.M. Annexins. New Phytol. 2011, 189, 40–53. [Google Scholar] [CrossRef] [PubMed]
- Balasubramanian, K.; Bevers, E.M.; Willems, G.M.; Schroit, A.J. Binding of annexin v to membrane products of lipid peroxidation. Biochemistry 2001, 40, 8672–8676. [Google Scholar] [CrossRef] [PubMed]
- Laohavisit, A.; Mortimer, J.C.; Demidchik, V.; Coxon, K.M.; Stancombe, M.A.; Macpherson, N.; Brownlee, C.; Hofmann, A.; Webb, A.A.R.; Miedema, H.; et al. Zea mays Annexins modulate cytosolic free Ca2+ and generate a Ca2+-permeable conductance. Plant Cell Online 2009, 21, 479–493. [Google Scholar] [CrossRef] [PubMed]
- Laohavisit, A.; Brown, A.T.; Cicuta, P.; Davies, J.M. Annexins: Components of the calcium and reactive oxygen signaling network. Plant Physiol. 2010, 152, 1824–1829. [Google Scholar] [CrossRef] [PubMed]
- Laohavisit, A.; Shang, Z.; Rubio, L.; Cuin, T.A.; Véry, A.A.; Wang, A.; Mortimer, J.C.; Macpherson, N.; Coxon, K.M.; Battey, N.H.; et al. Arabidopsis Annexin1 mediates the radical-activated plasma membrane Ca2+- and K+-permeable conductance in root cells. Plant Cell Online 2012, 24, 1522–1533. [Google Scholar] [CrossRef] [PubMed]
- Richards, S.L.; Laohavisit, A.; Mortimer, J.C.; Shabala, L.; Swarbreck, S.M.; Shabala, S.; Davies, J.M. Annexin 1 regulates the H2O2-induced calcium signature in Arabidopsis thaliana roots. Plant J. 2014, 77, 136–145. [Google Scholar] [CrossRef] [PubMed]
- Arpat, A.; Waugh, M.; Sullivan, J.P.; Gonzales, M.; Frisch, D.; Main, D.; Wood, T.; Leslie, A.; Wing, R.; Wilkins, T. Functional genomics of cell elongation in developing cotton fibers. Plant Mol. Biol. 2004, 54, 911–929. [Google Scholar] [CrossRef] [PubMed]
- Cantero, A.; Barthakur, S.; Bushart, T.; Chou, S.; Morgan, R.; Fernandez, M.; Clark, G.; Roux, S. Expression profiling of the Arabidopsis annexin gene family during germination, de-etiolation and abiotic stress. Plant Physiol. Biochem. 2006, 44, 13–24. [Google Scholar] [CrossRef] [PubMed]
- Feng, Y.M.; Wei, X.K.; Liao, W.X.; Huang, L.H.; Zhang, H.; Liang, S.C.; Peng, H. Molecular analysis of the annexin gene family in soybean. Biol. Plant. 2013, 57, 655–662. [Google Scholar] [CrossRef]
- He, M.; Yang, X.; Cui, S.; Mu, G.; Hou, M.; Chen, H.; Liu, L. Molecular cloning and characterization of annexin genes in peanut (Arachis hypogaea L.). Gene 2015, 568, 40–49. [Google Scholar] [CrossRef] [PubMed]
- Jami, S.K.; Dalal, A.; Divya, K.; Kirti, P.B. Molecular cloning and characterization of five annexin genes from Indian mustard (Brassica juncea l. Czern and coss). Plant Physiol. Biochem. 2009, 47, 977–990. [Google Scholar] [CrossRef] [PubMed]
- Lu, Y.; Ouyang, B.; Zhang, J.; Wang, T.; Lu, C.; Han, Q.; Zhao, S.; Ye, Z.; Li, H. Genomic organization, phylogenetic comparison and expression profiles of annexin gene family in tomato (Solanum lycopersicum). Gene 2012, 499, 14–24. [Google Scholar] [CrossRef] [PubMed]
- Yadav, D.; Ahmed, I.; Kirti, P.B. Genome-wide identification and expression profiling of annexins in brassica rapa and their phylogenetic sequence comparison with B. juncea and A. thaliana annexins. Plant Gene 2015, 4, 109–124. [Google Scholar] [CrossRef]
- Yan, H.; Luo, Y.; Jiang, Z.; Wang, F.; Zhou, B.; Xu, Q. Cloning and expression characterization of four annexin genes during germination and abiotic stress in Brassica rapa subsp. Rapa “tsuda”. Plant Mol. Biol. Report. 2016, 34, 467–482. [Google Scholar] [CrossRef]
- Ji, W.; Koh, J.; Li, S.; Zhu, N.; Dufresne, C.P.; Zhao, X.; Chen, S.; Li, J. Quantitative proteomics reveals an important role of gscbrlk in salt stress response of soybean. Plant Soil 2015, 1–20. [Google Scholar] [CrossRef]
- Zhang, H.; Han, B.; Wang, T.; Chen, S.; Li, H.; Zhang, Y.; Dai, S. Mechanisms of plant salt response: Insights from proteomics. J. Proteome Res. 2012, 11, 49–67. [Google Scholar] [CrossRef] [PubMed]
- Chu, P.; Chen, H.; Zhou, Y.; Li, Y.; Ding, Y.; Jiang, L.; Tsang, E.W.T.; Wu, K.; Huang, S. Proteomic and functional analyses of Nelumbo nucifera annexins involved in seed thermotolerance and germination vigor. Planta 2011, 235, 1271–1288. [Google Scholar] [CrossRef] [PubMed]
- Zhang, Y.; Xu, L.; Zhu, X.; Gong, Y.; Xiang, F.; Sun, X.; Liu, L. Proteomic analysis of heat stress response in leaves of radish (Raphanus sativus L.). Plant Mol. Biol. Report. 2012, 31, 195–203. [Google Scholar] [CrossRef]
- Steffen, J.G.; Kang, I.H.; Macfarlane, J.; Drews, G.N. Identification of genes expressed in the Arabidopsis female gametophyte. Plant J. 2007, 51, 281–292. [Google Scholar] [CrossRef] [PubMed]
- Wuest, S.E.; Vijverberg, K.; Schmidt, A.; Weiss, M.; Gheyselinck, J.; Lohr, M.; Wellmer, F.; Rahnenführer, J.; von Mering, C.; Grossniklaus, U. Arabidopsis female gametophyte gene expression map reveals similarities between plant and animal gametes. Curr. Biol. 2010, 20, 506–512. [Google Scholar] [CrossRef] [PubMed]
- Clough, S.J.; Bent, A.F. Floral dip: A simplified method for Agrobacterium-mediated transformation of Arabidopsis thaliana. Plant J. 1998, 16, 735–743. [Google Scholar] [CrossRef] [PubMed]
- Horsch, R.B.; Fry, J.E.; Hoffmann, N.L.; Eichholtz, D.; Rogers, S.G.; Fraley, R.T. A simple and general method for transferring genes into plants. Science 1985, 227, 1229–1231. [Google Scholar]
- Hiscox, J.D.; Israelstam, G.F. A method for the extraction of chlorophyll from leaf tissue without maceration. Can. J. Bot. 1979, 57, 1332–1334. [Google Scholar] [CrossRef]
- Heath, R.L.; Packer, L. Photoperoxidation in isolated chloroplasts: I. Kinetics and stoichiometry of fatty acid peroxidation. Arch. Biochem. Biophys. 1968, 125, 189–198. [Google Scholar] [CrossRef]
- Bates, L.; Waldren, R.; Teare, I. Rapid determination of free proline for water-stress studies. Plant Soil 1973, 39, 205–207. [Google Scholar] [CrossRef]
- Livak, K.J.; Schmittgen, T.D. Analysis of relative gene expression data using real-time quantitative pcr and the 2−ΔΔct method. Methods 2001, 25, 402–408. [Google Scholar] [CrossRef] [PubMed]
- Kumar, K.; Kirti, P. Differential gene expression in Arachis diogoi upon interaction with peanut late leaf spot pathogen, Phaeoisariopsis personata and characterization of a pathogen induced cyclophilin. Plant Mol. Biol. 2011, 75, 497–513. [Google Scholar] [CrossRef] [PubMed]
- Laohavisit, A.; Richards, S.L.; Shabala, L.; Chen, C.; Colaço, R.D.D.R.; Swarbreck, S.M.; Shaw, E.; Dark, A.; Shabala, S.; Shang, Z.; et al. Salinity-induced calcium signaling and root adaptation in Arabidopsis require the calcium regulatory protein Annexin1. Plant Physiol. 2013, 163, 253–262. [Google Scholar] [CrossRef] [PubMed]
- Faize, M.; Burgos, L.; Faize, L.; Piqueras, A.; Nicolas, E.; Barba-Espin, G.; Clemente-Moreno, M.; Alcobendas, R.; Artlip, T.; Hernandez, J. Involvement of cytosolic ascorbate peroxidase and Cu/Zn-superoxide dismutase for improved tolerance against drought stress. J. Exp. Bot. 2011, 62, 2599–2613. [Google Scholar] [CrossRef] [PubMed]
- Dalal, A.; Kumar, A.; Yadav, D.; Gudla, T.; Viehhauser, A.; Dietz, K.J.; Kirti, P.B. Alleviation of methyl viologen-mediated oxidative stress by Brassica juncea annexin-3 in transgenic Arabidopsis. Plant Sci. 2014, 219, 9–18. [Google Scholar] [CrossRef] [PubMed]
- Clark, G.B.; Rafati, D.S.; Bolton, R.J.; Dauwalder, M.; Roux, S.J. Redistribution of annexin in gravistimulated pea plumules. Plant Physiol. Biochem. 2000, 38, 937–947. [Google Scholar] [CrossRef]
- Clark, G.B.; Dauwalder, M.; Roux, S.J. Immunological and biochemical evidence for nuclear localization of annexin in peas. Plant Physiol. Biochem. 1998, 36, 621–627. [Google Scholar] [CrossRef]
- Kovács, I.; Ayaydin, F.; Oberschall, A.; Ipacs, I.; Bottka, S.; Pongor, S.; Dudits, D.; Tóth, É.C. Immunolocalization of a novel annexin-like protein encoded by a stress and abscisic acid responsive gene in alfalfa. Plant J. 1998, 15, 185–197. [Google Scholar] [CrossRef] [PubMed]
- Zhu, J.K. Salt and drought stress signal transduction in plants. Annu. Rev. Plant Biol. 2002, 53, 247–273. [Google Scholar] [CrossRef] [PubMed]
- Umezawa, T.; Fujita, M.; Fujita, Y.; Yamaguchi-Shinozaki, K.; Shinozaki, K. Engineering drought tolerance in plants: Discovering and tailoring genes to unlock the future. Curr. Opin. Biotechnol. 2006, 17, 113–122. [Google Scholar] [CrossRef] [PubMed]
- Sharma, S.; Villamor, J.G.; Verslues, P.E. Essential role of tissue-specific proline synthesis and catabolism in growth and redox balance at low water potential. Plant Physiol. 2011, 157, 292–304. [Google Scholar] [CrossRef] [PubMed]
- Dejardin, A.; Sokolov, L.; Kleczkowski, L. Sugar/osmoticum levels modulate differential abscisic acid-independent expression of two stress-responsive sucrose synthase genes in Arabidopsis. Biochem. J. 1999, 344, 503–509. [Google Scholar] [CrossRef] [PubMed]
- An, X.; Chen, Z.; Wang, J.; Ye, M.; Ji, L.; Wang, J.; Liao, W.; Ma, H. Identification and characterization of the Populus sucrose synthase gene family. Gene 2014, 539, 58–67. [Google Scholar] [CrossRef] [PubMed]
- Park, J.M.; Park, C.J.; Lee, S.B.; Ham, B.K.; Shin, R.; Paek, K.H. Overexpression of the tobacco tsi1 gene encoding an EREBP/AP2-type transcription factor enhances resistance against pathogen attack and osmotic stress in tobacco. Plant Cell 2001, 13, 1035–1046. [Google Scholar] [CrossRef] [PubMed]
- Zhai, Y.; Wang, Y.; Li, Y.; Lei, T.; Yan, F.; Su, L.; Li, X.; Zhao, Y.; Sun, X.; Li, J. Isolation and molecular characterization of Gmerf7, a soybean ethylene-response factor that increases salt stress tolerance in tobacco. Gene 2013, 513, 174–183. [Google Scholar] [CrossRef] [PubMed]
- Medina, J.; Catalá, R.; Salinas, J. The CBFs: Three Arabidopsis transcription factors to cold acclimate. Plant Sci. 2011, 180, 3–11. [Google Scholar] [CrossRef] [PubMed]
- Robert-Seilaniantz, A.; Grant, M.; Jones, J.D. Hormone crosstalk in plant disease and defense: More than just jasmonate-salicylate antagonism. Annu. Rev. Phytopathol. 2011, 49, 317–343. [Google Scholar] [CrossRef] [PubMed]
- Rangan, P.; Subramani, R.; Kumar, R.; Singh, A.K.; Singh, R. Recent advances in polyamine metabolism and abiotic stress tolerance. BioMed. Res. Int. 2014, 2014. [Google Scholar] [CrossRef] [PubMed]
- Groppa, M.; Benavides, M. Polyamines and abiotic stress: Recent advances. Amino Acids 2008, 34, 35–45. [Google Scholar] [CrossRef] [PubMed]
- Basu, S.; Roychoudhury, A.; Sengupta, D. Deciphering the role of various cis-acting regulatory elements in controlling samdc gene expression in rice. Plant Signal. Behav. 2014, 9. [Google Scholar] [CrossRef]
- Bitrián, M.; Zarza, X.; Altabella, T.; Tiburcio, A.F.; Alcázar, R. Polyamines under abiotic stress: Metabolic crossroads and hormonal crosstalks in plants. Metabolites 2012, 2, 516–528. [Google Scholar] [CrossRef] [PubMed]
- Urano, K.; Yoshiba, Y.; Nanjo, T.; Igarashi, Y.; Seki, M.; Sekiguchi, F.; Yamaguchi-Shinozaki, K.; Shinozaki, K. Characterization of Arabidopsis genes involved in biosynthesis of polyamines in abiotic stress responses and developmental stages. Plant Cell Environ. 2003, 26, 1917–1926. [Google Scholar] [CrossRef]
- Isayenkov, S. Physiological and molecular aspects of salt stress in plants. Cytol. Genet. 2012, 46, 302–318. [Google Scholar] [CrossRef]

© 2016 by the authors; licensee MDPI, Basel, Switzerland. This article is an open access article distributed under the terms and conditions of the Creative Commons by Attribution (CC-BY) license (http://creativecommons.org/licenses/by/4.0/).
Share and Cite
Yadav, D.; Ahmed, I.; Shukla, P.; Boyidi, P.; Kirti, P.B. Overexpression of Arabidopsis AnnAt8 Alleviates Abiotic Stress in Transgenic Arabidopsis and Tobacco. Plants 2016, 5, 18. https://doi.org/10.3390/plants5020018
Yadav D, Ahmed I, Shukla P, Boyidi P, Kirti PB. Overexpression of Arabidopsis AnnAt8 Alleviates Abiotic Stress in Transgenic Arabidopsis and Tobacco. Plants. 2016; 5(2):18. https://doi.org/10.3390/plants5020018
Chicago/Turabian StyleYadav, Deepanker, Israr Ahmed, Pawan Shukla, Prasanna Boyidi, and Pulugurtha Bharadwaja Kirti. 2016. "Overexpression of Arabidopsis AnnAt8 Alleviates Abiotic Stress in Transgenic Arabidopsis and Tobacco" Plants 5, no. 2: 18. https://doi.org/10.3390/plants5020018
APA StyleYadav, D., Ahmed, I., Shukla, P., Boyidi, P., & Kirti, P. B. (2016). Overexpression of Arabidopsis AnnAt8 Alleviates Abiotic Stress in Transgenic Arabidopsis and Tobacco. Plants, 5(2), 18. https://doi.org/10.3390/plants5020018
